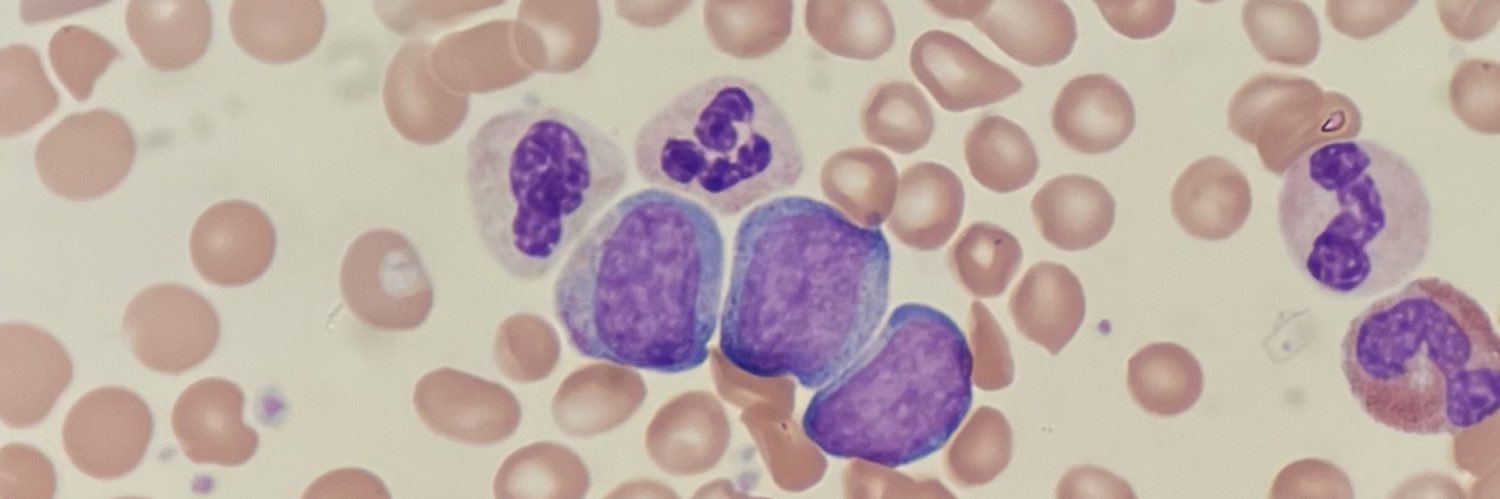
Charles Milrod, MD banner

Charles Milrod, MD
434 posts

Charles Milrod, MD
@CharlesMilrod
Medical director @AstraZeneca 🧬 | Hem/Onc MD via @The_BMC and @BrownUniversity | Interested in blood cancers, immunology, and coffee 🤙 Views my own




🎙️ Cancer Through My Eyes – Ep. 9 Meet Dr. @CharlesMilrod (@BrownUniversity), lymphoma researcher and Hem/Onc fellow pushing boundaries in immunotherapy dosing. 🧬 T-cell exhaustion 🫂 Patient-first trial design 🤝 Translational teamwork oncodaily.com/dialogues/canc… 💬 Got a question for our next guest? Or someone we should feature? Comment below — we’re listening. #CancerThroughMyEyes #OncoDaily #CharlesMilrod #Lymphoma #TCellExhaustion #HematologyOncology #Immunotherapy #BrownUniversity #CancerResearch #OncologyTwitter #PhysicianScientist #FutureOfOncology #MedTwitter #ClinicalTrials


















Congratulations to this year's class of Conquer Cancer Grant and Award recipients! We can't wait to celebrate with you at #ASCO24! Full list of recipients: brnw.ch/21wKdIf







In follicular lymphoma, is PFS a strong surrogate for OS? 🔊 NO! 🔑 PFS is the most commonly used surrogate for drug registration in FL 👎 PFS is *weakly* associated with OS 🤯 Only 15% of variance in OS is explained by PFS Read more in @BrJHaem 👇 onlinelibrary.wiley.com/share/author/F…




